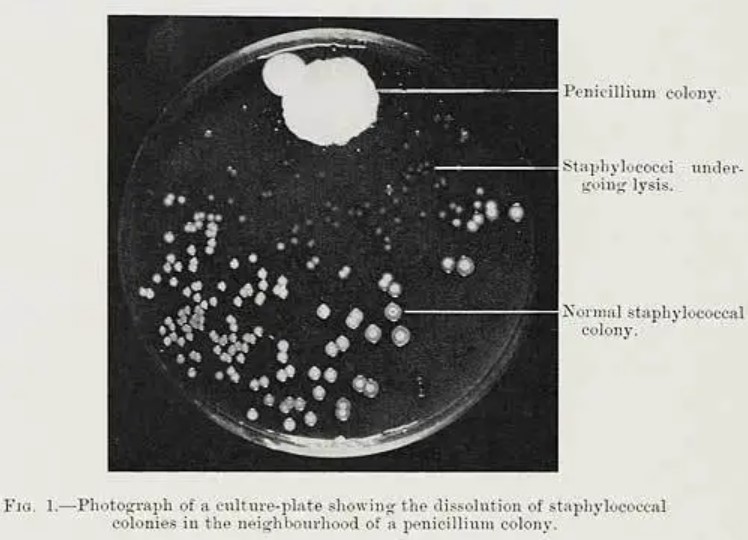
Image

药物606是六百零六次实验发现的吗?
来源:“饶议科学“微信公众号
犹太裔德国科学家Paul Ehrlich(厄立希,1854-1915)发明606,治疗梅毒,是化学治疗的成功范例。因此衍生了一些故事,其中望文生义的是606是六百零六次实验的结果。实际更有趣,但与六百无关。
抗菌药物极大改善了人类生存状况。经济发展带来的整体进步、疫苗、和抗生素可能是二十世纪人类寿命显著提高的三个最主要原因。厄立希参与了其中两方面的工作,抗体和抗菌药物,特别是在抗菌药物发明方面有开创性研究。
厄立希之前的科学家认识到药物分子需要直接结合其作用的对象(如抗菌药物需要结合病原菌),厄立希研究染料对病原菌的作用,其他人先发现砷剂的作用。厄立希确定有效砷剂的分子结构式,通过改造它获得衍生化合物,得到作用更强、副作用更小的药物。

化学治疗
厄立希推动实验治疗学发展,催生了“化学治疗”,并提出药物筛选的方法。
厄立希中学开始对科学感兴趣,特别是化学。比他大九岁的表哥Carl
Weigert(1845-1904)是病理学家,曾带还是中学生的厄立希去实验室看细胞染色。因德国的大学生可以自由转学,厄立希去过多个大学,从Breslau开始,转Strasbourg、Breslau、Leipzig。他接触到解剖学家Heinrich
Wilhelm von Waldeyer(1836-1921)、化学家Adolf
von Baeyer(1835-1917,合成靛蓝染料)、病理学家Julius
Cohnheim(1839-1884),遇到过当时还籍籍无名的乡村医生Robert
Koch(1843-1910)。在医学院期间,他研究了多种染料对组织、细胞的染色。23岁时,厄立希发表第一篇论文“苯胺染料及其显微技术中应用的知识贡献”(Ehrlich,1877)。24岁时发表医学博士论文题为“组织染色的理论与实践贡献”,第一部分为“染色的化学概念”,第二部分“苯胺染料及其化学、技术、组织学关系”(Ehrlich,1878),认为染色是化学反应、不是物理吸附,染色的特异性与染料的化学结构有关。生物化学反应动力学专家、米曼方程式提出者Leonor
Michaelis(1875-1949)认为厄立希在其博士论文就意识到外源物质通过化学结合细胞的物质是染色的本质,预见了侧链学说(Michaelis,1919)。科学史家Maria-Louise
Eckmann认为这一思想贯穿厄立希一生的研究(Eckmann,1959)。
医学院毕业后后厄立希到柏林的Charité医院工作十年,在血液学方面做出重要发现。
厄立希研究了机体对氧的需求,提出氧化还原与染色的关系。他的论文预示他今后的“侧链学说”(Ehrlich,1885)。1882年,Koch发现结核杆菌后,厄立希访问了Koch的实验室,发明了结核杆菌的染色方法。1885年厄立希在Charité医院的科室负责人去世,换了领导后,厄立希与其关系很不好。厄立希也患了结核,1888年病假后未回Charité医院。痊愈后,他在岳父资助下,自己开实验室,研究过可卡因,也研究了植物毒素。
1890年秋,当年的乡村医生的Koch已因为发现炭疽杆菌和结核杆菌而成为微生物学权威。他邀厄立希到其柏林的Moabit市立医院任职。Koch建立“传染病研究所”。1890年,研究所的Emil
von Behring和北里柴三郎在抗体研究突破之后,厄立希也在抗体研究有重要贡献。1896年厄立希得到支持建立“血清研究和检验研究所”,1899年,厄立希的研究所搬到法兰克福,改名为实验治疗研究所。研究所也支持和培养了英国药理学家Henry
Dale(1875-1968)等重要科学家。
厄立希对现代药物治疗学的作用,不亚于他对免疫学的作用。在理论上,他与“受体”概念的发展有关。在实践上,他提出可以筛选类似的化学分子,从中找到只杀感染病菌、而不影响人的药物,开创了化学治疗(chemotherapy):经典的化学治疗是用合成的化学分子直接作用于感染的病原菌(Dale,1960)。
药物分子化学结构与生物学活性的关系
厄立希在组织学、免疫学和药理学等多方面做出了重要的贡献。他的化疗工作与另两方面有联系。他首先集中精力的第一个领域是染色(Ehrlich,1956),组织染色固然是他发现一些细胞的基础,但也导致他研究结合病原菌的染料,从而认为分子结合是治疗的必要基础。他的第二个领域是免疫(Ehrlich,1959),而研究过程中提出受体的概念和积累治疗的经验,也为他第三个领域(化学治疗)打下了伏笔(Ehrlich,1960)。筛选化学分子的方法成为现代药物工业的基础。
厄立希的表哥Carl
Weigert是第一位用染料染细菌的科学家。这是厄立希从染料角度开始研究药物的缘由之一。与染料一样,药物作用需要直接接触的概念在厄立希之前已经知道。1881年,厄立希发现亚甲蓝可以染细菌(Ehrlich,1881)。1884年丹麦科学家Christian
Gram (1853-1938) 发明了对细菌分类迄今仍非常有用的革兰氏染色法。1885年,厄立希发现亚甲蓝注射到活体动物后染色神经系统(Ehrlich,1885)。1890年,他和Arthur
Leppman (1854-1897)用亚甲蓝治疗神经和风湿病(Ehrlich
and Leppman,1890)。1891年,Paul
Guttmann (1834-1893)和厄立希认为:亚甲蓝在体外可染导致疟疾的疟原虫,而亚甲蓝注射入体内可以进到红细胞,那么就有理由用亚甲蓝治疗疟疾。因此他们试了给两位病人(21岁的男仆和57岁的水手)注射亚甲蓝,都起了一定作用(Guttmann
and Ehrlich,1891)。不过其作用不如当时已经有的奎宁,所以没有推广,但给Ehrlich以后做化学治疗打下了基础。1902年,厄立希和日本来的志贺洁(Kiyoshi
Shiga,1871–1957)系统地筛选了几百种合成化合物对动物感染的治疗作用(Felsenfeld,1957)。1904年,他们发现锥虫红可以治疗锥虫感染,但锥虫会出现抗药性(Ehrlich
and Shiga,1904)。
药物构效关系的研究由德国和英国科学家所开创(Ehrlich,1898)。1859年,德国化学家Carl
Stahlschmidt(1831-1902)发现士的宁分子甲基化后,不再引起肌肉强直,而产生类似筒箭毒的毒性(Stahlschmidt,1859)。英国爱丁堡大学的有机化学家Alexander
Crum Brown (1838-1922)和Thomas
Fraser(1841-1920)在此基础上合成一系列化合物,发现化学结构与生物活性的关系(Crum-Brown
and Fraser,1868,1869)。
厄立希率先利用已知的药效关系,发明药物筛选方法(Riethmiller,2005)。
药物分子的筛选
厄立希的方法分两步:首先找到一个有治疗作用的化学分子(现在称为先导化合物),第二步是对它进行化学修饰和改造,获得一大批衍生分子,通过筛选找到作用最佳、副作用最弱的分子(Ehrlich,1907;1910)。厄立希的方法迄今仍然广泛使用(Kaufmann,2008)。
导致非洲昏睡病的锥虫,是厄立希首创方法的应用领域。当时锥虫病研究主要是法国巴黎的巴斯德研究所、英国利物浦的热带医学学院、和德国法兰克福的Georg-Speyer研究所。当时找到三类治疗锥虫病的分子:二苯甲胺类染料(其中副台红效果最好)、联苯胺(其中以锥虫红最佳)、砷剂(Ehrlich,1907)。应用砷剂治疗锥虫病是发现疟原虫导致疟疾的法国医生Alphonse
Laveran (1845–1922)。他也发现非洲嗜睡病的病因是锥虫。1903年,他发现砷剂对锥虫病有作用,但在体内效果不佳,可与锥虫红联合用药(Ehrlich,1906)。1905年,在英国利物浦热带医学院工作的加拿大医生Harold
Thomas(1875-1931)与同事Anton
Breinl(1880-1944)发现含砷的化合物atoxyl在动物实验中对锥虫病有作用(Thomas
and Breinl,1905)。
1903年,厄立希和志贺洁也曾试过atoxyl,但在试管中没有观察到其对锥虫的作用,因而放弃了。在得知英国的结果后,厄立希决定寻找相关的新分子,试图得到治疗作用更好、毒性更低的药物(Ehrlich,1910)。
Atoxyl是由当时在法国Montpellier大学工作的Antoine
Béchamp(1816-1908)所合成的,他认为其化学结构是砷酸和苯胺的酰胺(Béchamp,1863)。厄立希与Alfred Bertheim (1879-1914)发现atoxyl其实是对氨基苯砷酸(Ehrlich
and Bertheim,1907; Ehrlich,1907)。虽然是同分异构体,这两种结构有相当大的差别。

在理解了atoxyl的正确结构后,厄立希和Bertheim进行了结构修饰,制造了一大批化合物。因为氨基在苯环对面位置,所以很容易修饰。例如,在氨基上加乙酰得到arsacetin(亦称acetylatoxyl)编号为306,其治疗作用提高,在小鼠可达百分之百(Ehrlich,1907),但有其他毒性。他们还合成了其他分子,并检测了其对锥虫病的治疗作用,有些如408(偶砷苯基甘氨酸)作用提高、副作用减少。

1905年,德国动物学家Fritz
Schaudinn (1871–1906) 和医生Erich
Hoffmann (1868–1959)发现梅毒的致病原因是梅毒钩端螺旋体,Hoffmann建议厄立希试用砷剂治疗梅毒。厄立希忙于锥虫病,在1907和1909年没进行过梅毒的治疗,但把自己已有的砷剂给发现淋病病原体的朋友Albert
Neisser (1855-1916),请他在梅毒的猴子模型上检验治疗作用,给Neisser的分子之一是606(第六批化合物的第六个分子),Neisser没有发现其治疗作用。

在锥虫病治疗告一段落后,也有了日本北里柴三郎推荐的学生秦佐八郎(Sahachiro
Hata,1873-1938)到厄立希实验室做助手,厄立希决定专注梅毒治疗(Ehrlich,1910)。1909年秦佐八郎用兔的梅毒模型筛选厄立希研究所已有的砷剂。他发现:606具有显著的治疗梅毒的作用(Ehrlich
and Hata,1910)。早在1907年,厄立希研究所的Bertheim就合成了的606,化学名称为二羟基二氨基联砷苯(亦称arsphenamine,胂凡纳明,商品名Salvarsan)。但等到秦佐八郎才发现其治疗梅毒的作用。经过更多的动物实验和人类试验后,厄立希和秦佐八郎于1910年在“内科学大会”报告606的作用,引起极大反响,各地立即有很多要求进行进一步试验。广泛的验证证明606确实有治疗梅毒的作用,其推广使得五年内欧洲的梅毒减少到一半。不过也有人反对应用,俄国东正教曾认为梅毒是神对不道德者的处罚,不应该治疗。
606也有副作用和其他问题。1914年,合成了水溶性较好、副作用较小的914。1930年,发现厄立希实验室以前合成的599效果更好。自此至青霉素应用之前,599是治疗梅毒的最常用药物。
厄立希于1906年提出“魔弹”的概念:理想的魔弹是只对病原体有亲和力并起损害或杀伤作用,而对人体没有亲和力、亦无损伤作用(Ehrlich,1906)。606是一例,914、599更符合。
606开创了抗生素革命(Gensini, Conti and Lippi,2007;Bosch
and Rosich,2008)。1932年,德国的Gerhard
Domagk(1895-1964)用厄立希同样方法筛选治疗细菌性感染的过程中,发现含磺胺的红色染料可以治疗小鼠的链球菌感染。他于1935年发表这些结果,这一分子以后商品名为百浪多息,代表磺胺类抗生素的诞生。
1928年9月3日,英国伦敦圣玛丽医院的Alexander
Fleming (1881-1955)旅游回实验室后发现在一个培养皿中葡萄球菌生长在一边,而另外一边出现了霉菌感染,靠近霉菌的培养基上面没有葡萄球菌生长。他注意到这一偶然现象,进一步研究发现特定的霉菌(青霉菌)可以产生对热不敏感的分子,抑制一些种类的细菌(但不抑制其他细菌)的生长。
青霉菌分泌的抑菌分子,被德国移民英国的犹太科学家Ernst
Chain (1906-1979)和澳大利亚移民英国的Howard
Florey (1898-1968) 以及他们的同事最有效的提取。1940年5月25日,他们用部分纯化的分子在小鼠实验证明有效,以后进一步得到验证,他们称其中的化疗物质为“青霉素”(Chain et
al.,1940)。1941年1月他们第一次将青霉素用于人的细菌感染,观察到了显著的治疗作用,以后被一系列试验所验证(Abraham et
al.,1941)。经过一系列工作,他们和同事最终获得了纯化的青霉素。

青霉素的特异性远高于砷剂,更符合所谓魔弹的描述。青霉素可以治疗一批当时常见的病原菌感染,是人类的福音。其后链霉素(Schatz, Elizabeth and Waksman,1944)、氯霉素(Ehrlich et al.,1947)、四环素(Duggar,
1948;Finlay et
al.,1950;Stephenset al.,1952;Conover et al.,1953)、红霉素(McGuireet al.,1952)、万古霉素(McCormick et
al., 1956)、庆大霉素(Weinsteinet
al.,1963)等等如雨后春笋不断被发现,各有特色,控制了很多感染性疾病,特别是细菌和真菌感染。
虽然今天有更多的寻找药物的方法,但二十世纪初所用的药物筛选方法仍然沿用至今,为合理药物设计的重要方法之一。
在理解吗啡化学结构的基础上,人工合成多种衍生分子(Beckett,1952),其中一些失去活性。失去活性的与有活性的分子,有些差别很小:分子式一样、只是立体结构有差别的立体异构分子,可以一个有活性,另一无活性。有些衍生物与吗啡作用类似,为吗啡激动剂。有些衍生物本身不引起生理学反应但可以抑制吗啡的作用,为吗啡拮抗剂,如naloxone等(Kosterlitz and Watt,1968)。
(来自《生物学概念与途径》第十章2021版:http://www.raolab.org/upfile/file/20200612163741_435711_91529.pdf )